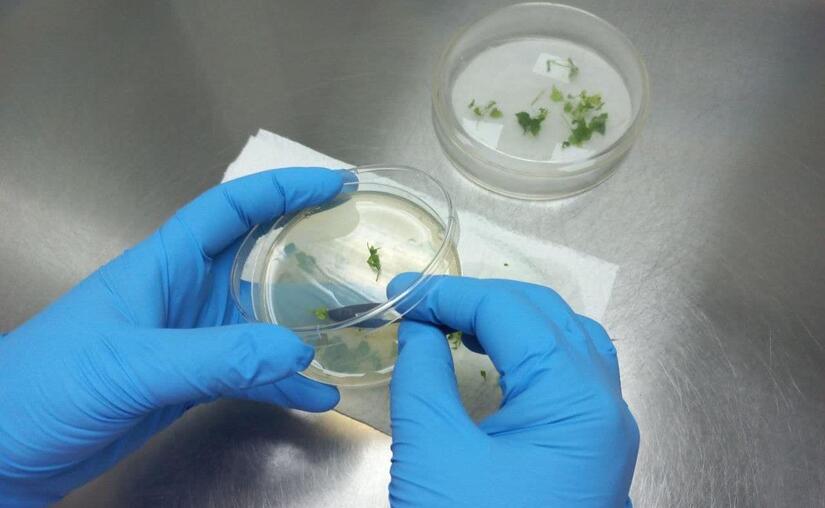
INTA5

El Instituto Nicaragüense de Tecnología Agropecuaria, INTA, continúa desarrollando su Estrategia Nacional de Bioinsumos para el fortalecimiento de la Producción Agropecuaria Sostenible y Agroecológica a través de la investigación, producción y aplicación de insumos biológicos.
Hasta la fecha se han realizado 38 investigaciones e implementado 5 tecnologías a disposición de las Familias productoras para el incremento de la producción agropecuaria; contamos con 5 laboratorios especializados desde donde anualmente se producen más de 15,000 dosis de Bioinsumos y 7 módulos a nivel nacional para la identificación, multiplicación y producción de microorganismos benéficos.
Entre estas investigaciones se destacan las bacterias que solubilizan o liberan el fósforo presente en el suelo, reduciendo los costos de producción al incorporar menos fertilizante químico; el uso de Trichoderma nativas para potenciar el sistema radicular en los cultivos.

Uso de bacterias fijadoras de fósforo y nitrógeno en los cultivos de arroz y frijol, para el crecimiento vegetativo de las plantas, la fertilización y rendimiento. De igual manera, se desarrollan formulaciones bajo sustrato semiartesanal para la multiplicación del Bacillus thuringiensis, bio insecticida que el INTA promueve para el manejo del gusano cogollero en el maíz, una de las principales plagas que afectan este cultivo en nuestro País.
También se investigan 200 cepas nativas de microorganismos colectadas, para determinar el potencial y seleccionar las mejores que contribuyan a la fertilización de cultivos, promuevan el desarrollo de las plantas, controlen plagas y enfermedades y mejoren la salud del suelo.
En lo que va de este año, se han capacitado a 2,873 productores en temas sobre producción de bioinsumos, abono orgánico, uso, multiplicación y aplicación de sustrato enriquecido con micorrizas y thichoderma, uso de Bacillus subtilis para el control de enfermedades, entre otros.